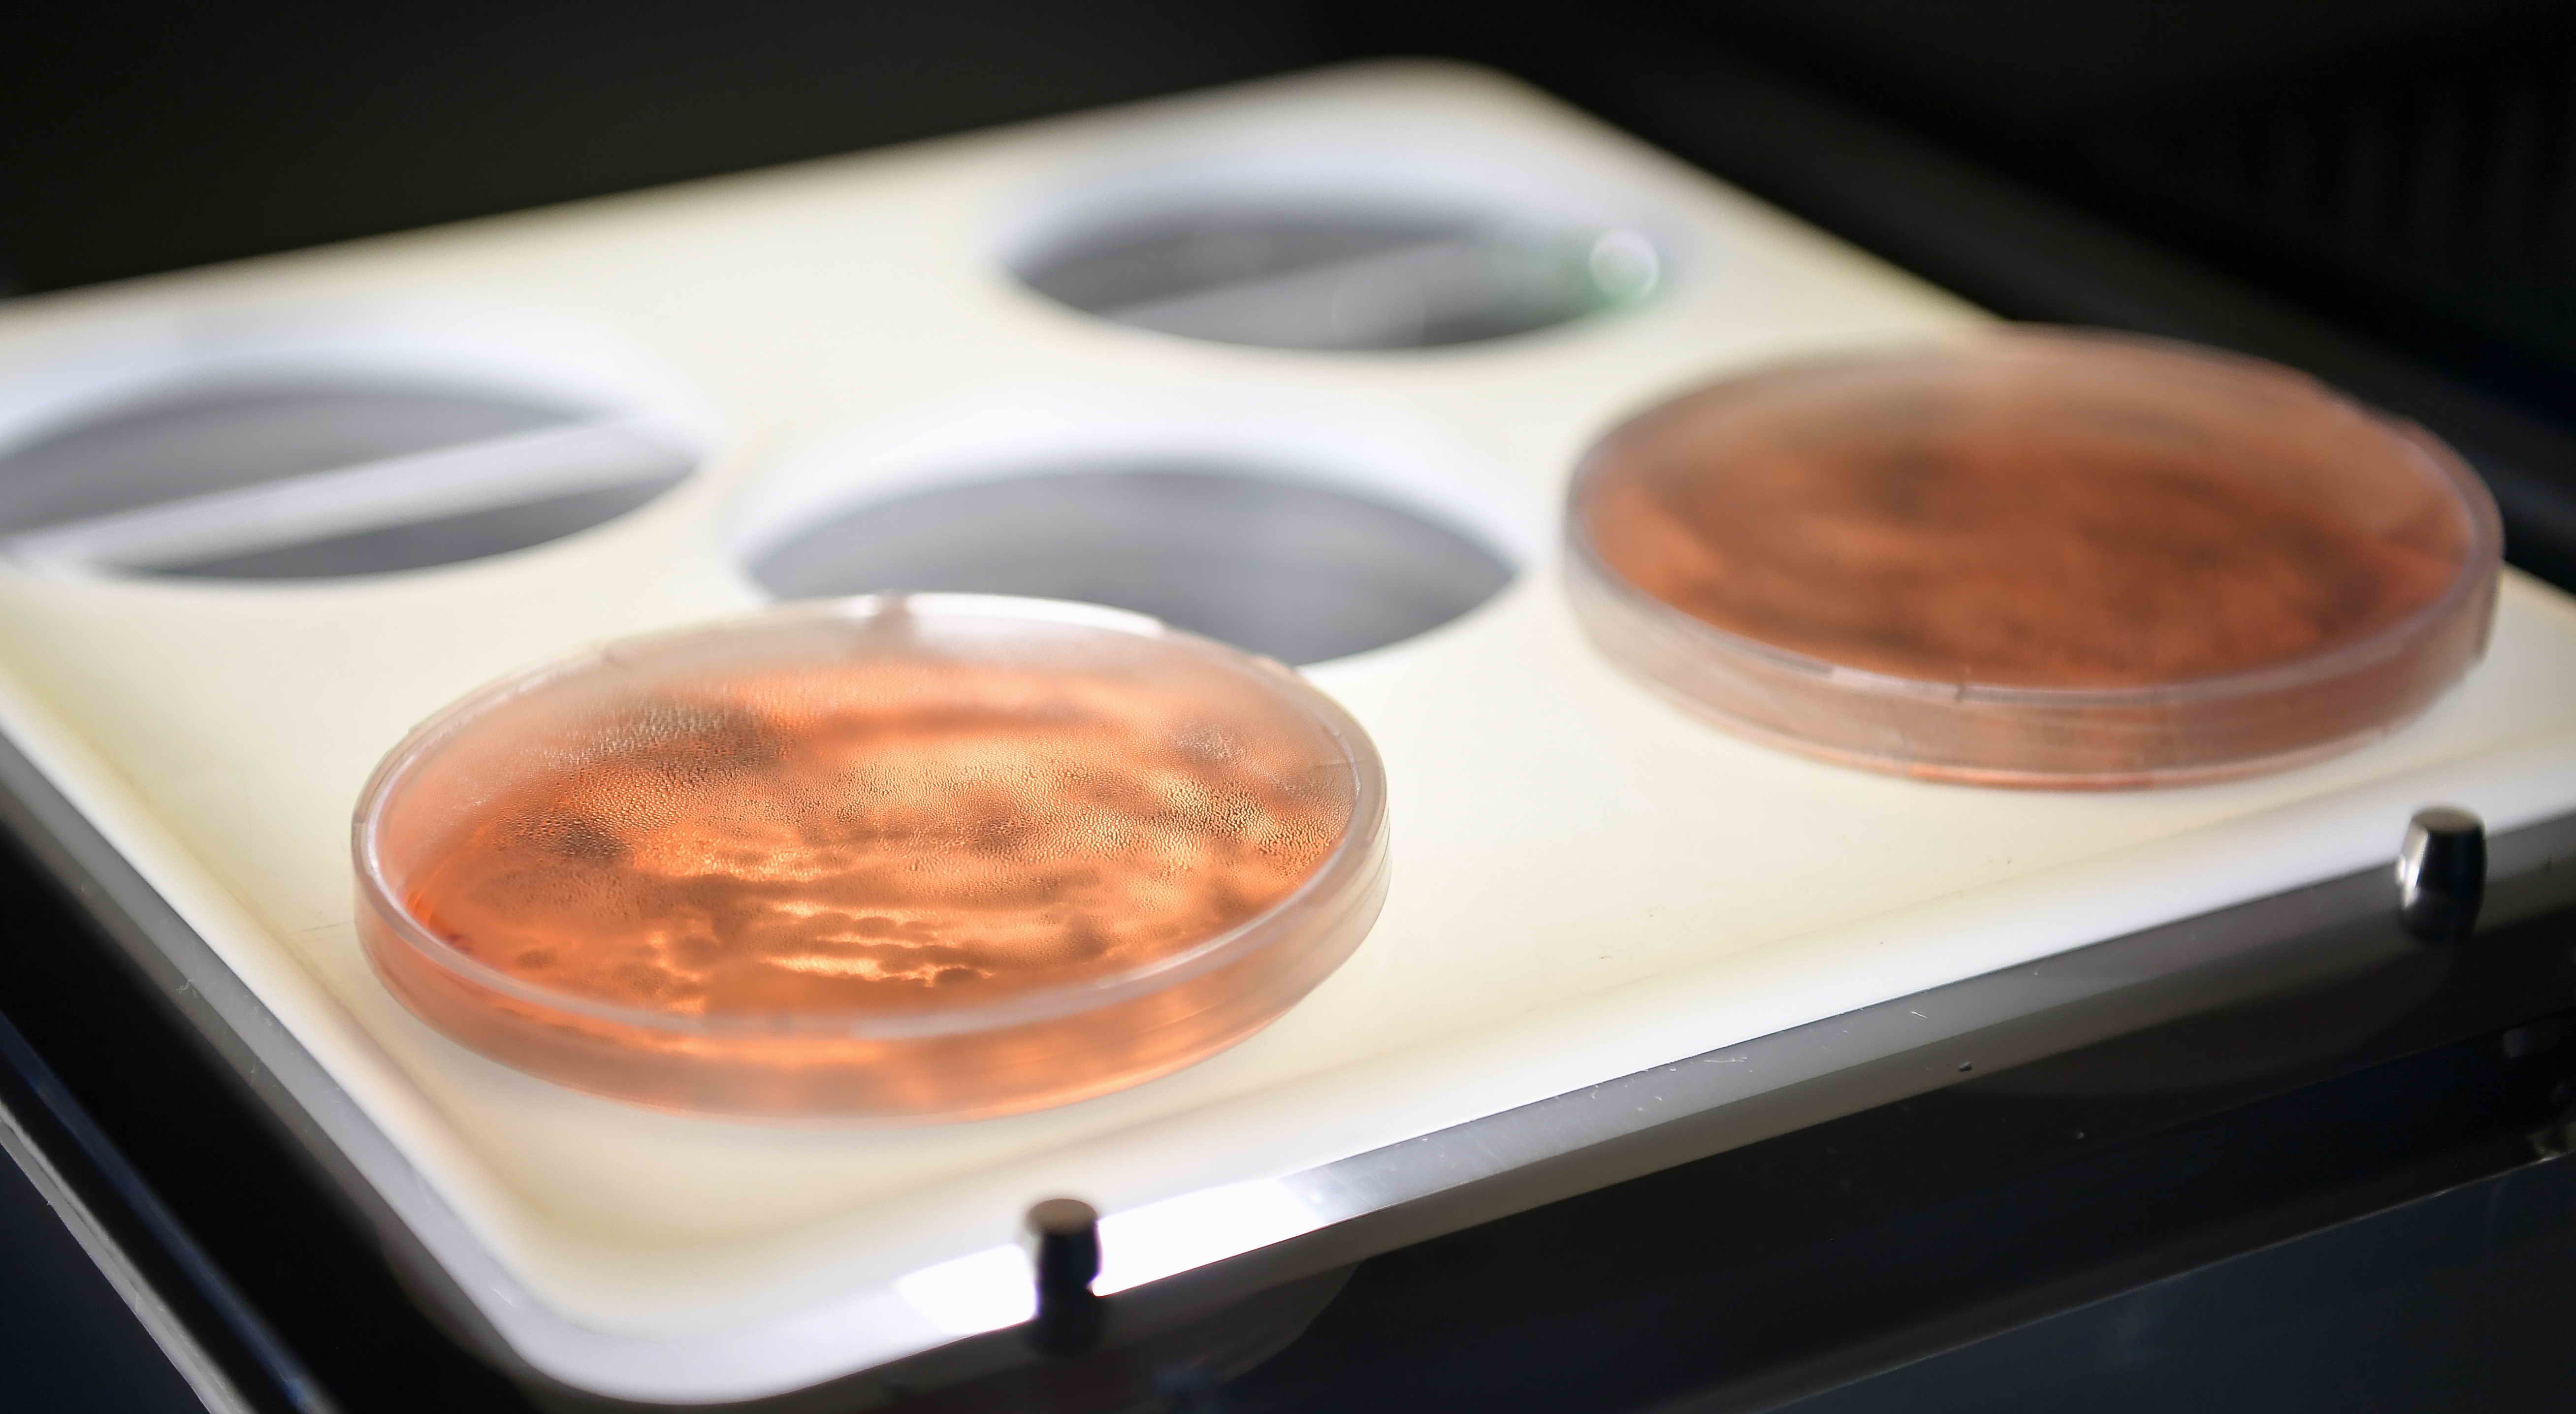

The Head of State got acquainted with the research work of scientists of the National Centre for Biotechnology.
Employees of the Centre presented the President a test system based on polymerase chain reaction (PCR), which was developed by artificial DNA synthesis (without a “live” strain) and allows quickly detect a new type of coronavirus. The high sensitivity of the test system in comparison with foreign diagnostic drugs was confirmed.
Currently, given the need to ensure the biological safety of Kazakhstan and the ability of COVID-19 to adapt to various climatic conditions, scientists of the National Centre for Biotechnology, together with the Research Institute of Biological Safety, have started work on creating a vaccine against coronavirus.
Kassym-Jomart Tokayev highly appreciated the work of biologists and noted the importance of their own developments to improve the competence of Kazakhstan's science.
“In fact, the laboratory is unique for Kazakhstan. We have high hopes for your work. We will help you. The virus itself and its spread have shown that the state should pay more attention to the activities of biological laboratories, medical and sanitary services,” President Tokayev said.
The Head of State recalled the need to comply with the requirements of the quarantine.
“Addressing the citizens, I would like to say that we need to observe the quarantine. On the other hand, people should not panic in any case, because since ancient times, epidemics have avoided those places where optimism and cheerfulness reign, and people do not get discouraged. At the same time, infection affects those who are prone to depression and pessimism, so you need to stick together. As for those infected, they will not be rejected. They will receive appropriate treatment, and we will take care of them and those who are in quarantine,” the President stressed.
Kassym-Jomart Tokayev noted that a large-scale action plan was unveiled at a meeting of the State Commission on a State of Emergency, which includes a package of financial assistance to the population, including business communities.
“The total cost of this package, not including tax preferences and measures to reduce the credit burden, is an unprecedented amount, more than $10 billion. And now we are faced with the task of spending these funds very effectively. We will work it out. The situation is under control, our citizens understand that they are taken care of, and this is the priority of our activities,” President Tokayev concluded up his speech.
During the visiting the Centre, Minister of Education and Science Askhat Aimagambetov, Minister of Health Yelzhan Birtanov, as well as General Director of the National Centre for Biotechnology Yerlan Ramankulov made a report to the President.
Earlier, Russian scientific organizations developed vaccines against avian and swine flu, nodular dermatitis and vector-based brucellosis in a short time. In total, 28 types of vaccines and technologies of diagnostic test systems have been developed. Some of them are supplied to foreign countries.